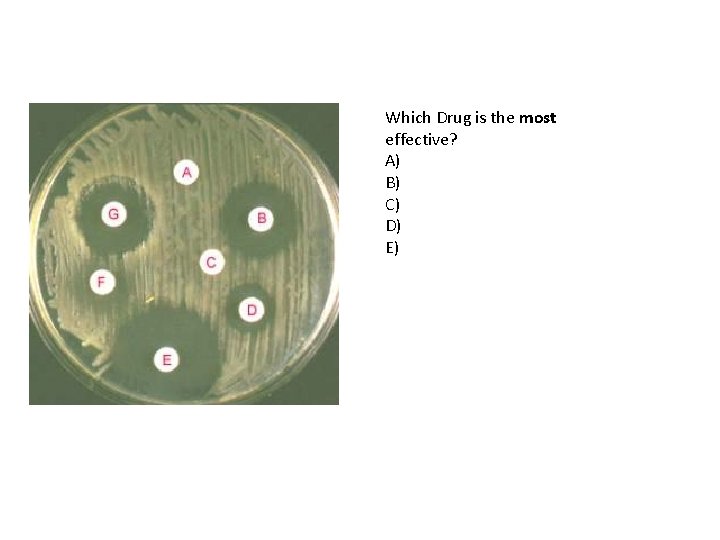
Which Drug is the most effective? A) B) C) D) E)
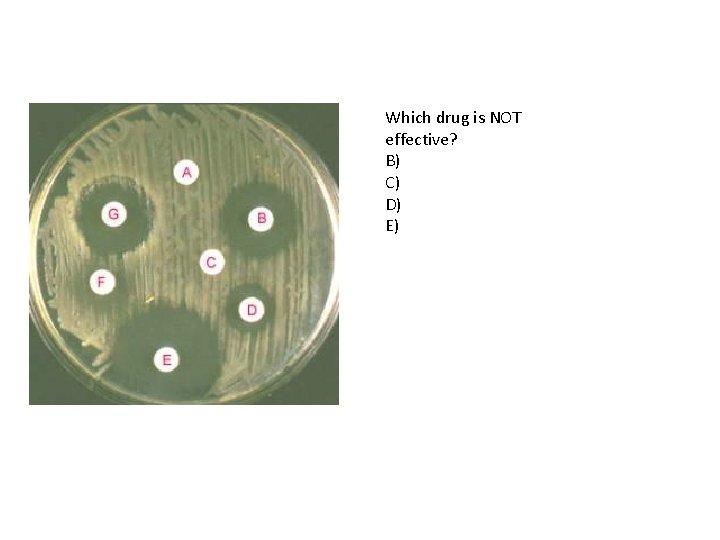
Which drug is NOT effective? B) C) D) E)
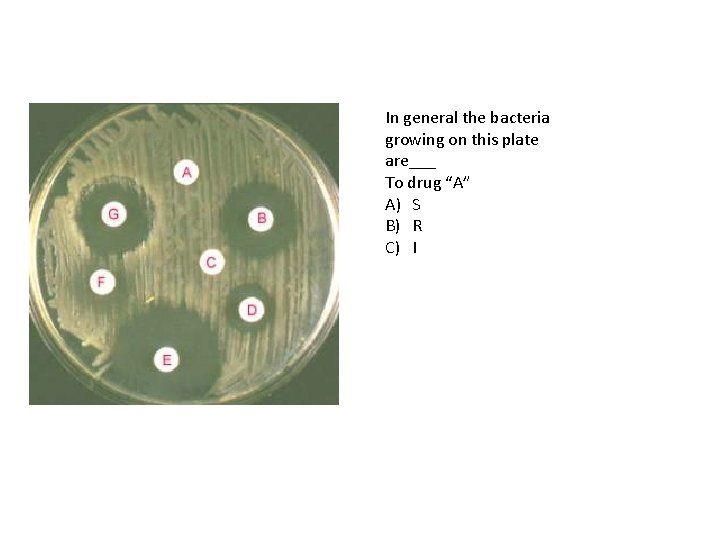
In general the bacteria growing on this plate are___ To drug “A” A) S

Chemical Control Methods Chemotherapy The Spectrum of Antimicrobial

Chemical Control Methods Chemotherapy

The Spectrum of Antimicrobial Activity • = range of organisms affected by a drug Broad • _______ spectrum antibacterial drug affects both gram + and gram – organisms Narrow • _______ spectrum drug affects one or the other • See table 20. 2


Broad vs. Narrow • advantage of broad spectrum: more likely to affect an unidentified pathogen • disadvantage of broad spectrum: more damage to beneficial normal flora; greater chance of superinfection (infection by a second pathogen)

• Competition, Predator/Prey Models

Concept of selective toxicity • the obvious part: a drug must be more toxic to the pathogen than to the host • HOW? Drug affects some aspect of the pathogen’s physiology that is not part of the host’s physiology examples: block an enzyme that only the pathogen has; block formation of cell wall (we have none) • some common actions:

Awesome Essay Question!!!

1. Inhibitors of Cell Wall Synthesis • An attractive target for the action of antibiotics…why?

cell wall damage by antibiotic • before antibiotic after antibiotic

Remember the definition for antibiotic? • A substance produced by microbes that in small amounts inhibits another microbe • See table 20. 1

Penicillin as an example

Penicillinases (beta-lactamases) • Bacterial enzymes that destroy natural penicillins • Semisynthetic penicillins are made to resist penicillinases and have a broader spectrum of activity than natural (fungal made) penicillins

2. Inhibitors of Protein Synthesis • Tetracyclines as the example – Broad-spectrum antibiotics produced by Streptomyces spp. – 70 S prokaryotic ribosome that tetracycline targets!

3. Competitive Inhibitors of bacterial enzyme function • Let’s use sulfonamides (sulfa drugs) as the example • First synthetic antimicrobial drugs used to treat microbial diseases • Bacteriostatic in action • Molecules are similar to paraaminobenzoic acid (PABA)

sulfonamide action • in bacteria but not in people: PABA enzyme: blocked by sulfonamide Folic acid (vitamin)

Synergism and antagonism Synergism = combined effect of two • ______: drugs used at same time is greater than the sum of their individual effects: 2 + 2 = 8 (next slide example) Antagonism = combined effect of two • ______: drugs used at same time is less than the sum of their individual effects: 2 + 2 = 0 – E. g. Tetracycline is bacteriostatic and interferes with the action of penicillin…. why?

TMP-SMZ : Sulfa drug synergism

-cidal vs -static • -cide or -cidal refers to killing, e. g. : • -stasis or -static refers to inhibition without killing, e. g. • static effect often adequate: drug slows down pathogen; body defenses clean it up cidal effect static effect

Susceptibility testing • done to determine which drugs might control an infection • several methods. This is the Kirby-Bauer disk-diffusion method:

Kirby-Bauer : test to guide chemotherapy Petri plate with pure culture of pathogen: zone of _____ inhibition susceptibility disk

• Results reported as: S (sensitive) = drug worked well – ___ I (intermediate) or MS (moderately – ___ susceptible) = drug worked a little R (resistant) = drug did not affect organism – ___ • Simple and inexpensive but has limitations
Which Drug is the most effective? A) B) C) D) E)
Which drug is NOT effective? B) C) D) E)
In general the bacteria growing on this plate are___ To drug “A” A) S B) R C) I


Drug Resistance • pathogen is not affected by a drug – opposite of susceptibility (a drug affects a pathogen) • develops with every class of pathogen • it is the PATHOGEN that changes: not the drug and not the host – we (hosts) may develop an allergy, but not a drug resistance

Drug resistance develops in the • Pathogen • The lack of susceptibility of a microbe to a chemotherapeutic agent ≠

How Drug Resistance Develops • a. selection & evolution: every time a drug dosage kills less than 100%, the survivors are the most drug resistant individuals (re: genetic variability in initial population)

• b. pathogen changes (mutations) so it is not affected by the drug – develops a way to inactivate the drug, such as penicillinase (beta-lactamase) – prevents the drug from reaching its target site within the pathogen – blocks entry of the drug into the cell – target site changes, e. g. a new enzyme appears that does same job but is not affected by the drug – Rapid efflux (ejection), which pumps the drug out of the cell before it can become effective

• If you are given an antibiotic and you do NOT finish taking your prescribed dosage of the antibiotic, which of the following is most likely to happen? • A) That antibiotic will not be as effective for fighting future infections because you body will have adapted to the drug. • B) That antibiotic will not be as effective in several weeks against that same infection (should you relapse) because the bacteria will be more resistant to the drug. • C) The normal flora of microbes are more likely to evolve and become pathogens because of competition that results from stopping a drug before the initial infection was destroyed. • D) Nothing will happen. As long as you are feeling better at the time in which you stop taking your antibiotic, your infection will be gone.

Figure 20. 20 Another great essay!

• c. recombination: drug resistance genes travel from pathogen to pathogen


Development of an antibioticresistant mutant during antibiotic therapy (fig. 20. 21)

How to delay resistance • probably can’t prevent, only delay resistance • a. avoid unnecessary or inappropriate drug use – unnecessary: using drug for minor infection that the body defenses would clean up – inappropriate: using antibacterial drug for a viral infection • b. when using a drug, use full dosage (to avoid leaving resistant survivors) • c. in long-term use, rotate drugs • d. minimize use of antibiotics in animal feed to promote growth
- Slides: 35